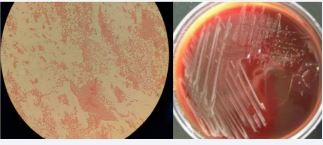

Establishment of Standardized Diagnostic System for Brucella Spondylitis in the Elderly and Clinical Application of Precise Treatment Strategy
- 1. Department of Orthopaedics. The First Affiliated Hospital of Hebei North University Zhangjiakou 075000, Hebei Province, China
- 2. Graduate School of Hebei North University, Zhangjiakou 075000, Hebei Province, China
Abstract
Objective: Establish a clinical standardized diagnosis and treatment strategy system for senile brucellosis spondylitis, and evaluate the clinical effect of applying this diagnosis and treatment system in order to improve the diagnosis rate and cure rate of the disease.
Methods: From January 2002 to December 2017, 70 elderly patients with brucellosis spondylitis were treated, and comprehensively diagnosed by medical history, clinical, imaging, laboratory and pathology. Among them, the positive rates of Rose Bengal Plate Agglutination Test (RBPT), Standard Tube Agglutination Test (SAT) and brucellosis anti-human immunoglobulin test (Coomb’s) were 45.71%, 70% and 100%, respectively. All patients in this group underwent X-ray films, CT and MRI examinations; pathogenic examinations: blood culture, bone marrow culture, and inflammatory granuloma (or abscess) sampling and culture positive rates in the lesion were 17.14%, 39.66%, and 52.38%, respectively. All patients received standardized drug therapy, anti-osteoporosis therapy, and adjuvant hyperbaric oxygen therapy. Among them, 42 patients with neurological impairment received one-stage lesion debridement combined with posterior spinal internal fixation surgery on the basis of drug therapy. The paravertebral abscess area and diseased intervertebral space tissues were taken for pathological examination. According to evaluation items, patients in this group were selected as follow-up and evaluation points at different time points after treatment: 2 weeks, 1 month, 3 months, 6 months and 12 months. Evaluation items include VAS score, imaging score, and clinical efficacy evaluation. SPSS15.0 statistical software package was used for analysis.
Results: All patients were confirmed by the above comprehensive examination after admission. In this group, 28 cases (40%) met conservative treatment and received standardized chemotherapy (Group A), and the remaining 42 cases (60%) were complicated with neurological impairment of varying degrees. After 2 to 4 weeks of drug treatment, the symptoms did not improve, and they met the surgical indications and underwent surgical treatment, (Group B). VAS scores showed that there was a statistically significant difference between the two groups at the same time point after treatment (P < 0.05), and group B was superior to group A in terms of time and pain relief. Imaging scores showed that in the late stage of group B, except for the slow bone repair in the debridement area of the original spinal lesion, the spinal lesion segments were stable, and there were no abscesses and inflammatory granulomas; the infiltration of vertebral body lesions and the absorption of intervertebral space infection in group A were not obvious 3 months after treatment, but the inflammatory infiltration of vertebral body and intervertebral space infection gradually absorbed after 6 months. Clinical efficacy evaluation showed that with the passage of time, both groups could obtain good cure rates, and there was statistical significance in clinical cure rates difference between group B and group A (P < 0.05), indicating that both groups of treatment methods had good effects, and group B was better than group A.
Conclusion: Elderly brucellosis spondylitis has characteristic manifestations, and the establishment of a standardized diagnosis system will help improve the diagnosis rate; Synchronous drug therapy for BS and osteoporosis according to the treatment strategy has a good effect, and for patients who meet the indications for surgery, timely surgery can relieve or relieve pain, maintain spinal stability, and promote rapid recovery of nerve and spinal functions. It has obvious advantages and can better improve the clinical cure rate.
Keywords
• Brucellosis
• Spondylitis
• Standardized diagnosis
• Treatment strategy
• Diagnosis and treatment system
• Clinical evaluation
CITATION
Xinming Y, Zhe Z, Chaowei Y, Xuyang Z (2023) Establishment of Standardized Diagnostic System for Brucella Spondylitis in the Elderly and Clinical Application of Precise Treatment Strategy. JSM Neurosurg Spine 10(1): 1111.
INTRODUCTION
Brucellosis Spondylitis (BS) is a specific, infectious spondylitis caused by zoonotic and infectious Brucella invading the spine. Due to the insensitivity of the body’s response ability in the elderly, the early clinical symptoms are not typical, and the imaging findings are easily confused with spinal tuberculosis, which can easily lead to misdiagnosis and mistreatment. This disease is an important endemic disease that causes severe limitation of spinal function in the elderly [1,2]. Familiarity with the clinical characteristics of BS and related diagnosis and treatment plans can play a positive role in the prevention and treatment of the disease. The author retrospectively analyzed 70 elderly patients with complete clinical data and follow-up data of BS admitted to our hospital from January 2002 to December 2017, and achieved good results through the implementation of a systematic diagnosis and treatment plan and curative effect evaluation. The report is as follows.
DATA AND METHODS
The Research Object
A total of 70 elderly patients with BS diagnosed in the First Affiliated Hospital of Hebei North University from January 2002 to December 2017 were selected as the research objects. According to the literature BS non-surgical and surgical indications were divided into two groups [3], non-surgical treatment group 28 Patients (group A) received standardized drug-only non-surgical treatment, including 20 males and 8 females, aged 65-81 years, with an average of 70.3 ± 0.5 years, and the onset time was 3-11 months, with an average of 6.8 ± 0.3 months. The treatment group included 42 cases (group B), 30 males and 12 females; aged 65-82 years, with an average of 70.4 ± 0.4 years, and the onset time was 3-12 months, with an average of 6.9 ± 0.2 months. All the patients in this group had a history of contacting cattle and sheep, drinking unsterilized emulsion and eating beef and mutton. Among them, 23 patients lived in brucellosis endemic areas, and 4 of them had a history of distal radius fractures (2 cases) and proximal humerus fractures (2 cases) that have been cured. At the time of treatment, the patient presented with persistent severe lumbar and back pain, obvious tenderness and tapping pain in the lesion area, muscle spasm, waist rigidity and extreme restriction in activity, afraid to walk while holding the waist with both hands, and afraid to turn over in bed. The patient was in a passive or fixed position, but no kyphosis of the spine. 22 patients showed relaxation fever (body temperature ≤ 38.5?) and night sweat.
When 70 outpatients in this group visited the doctor for the first time, 64 cases were diagnosed as lumbar tuberculosis. The number and location of vertebral bodies involved in lesions: 60 cases of lesions invaded 2 vertebral bodies, including 12 cases of lumbar 3 lumbar 4 vertebral bodies, 34 cases of lumbar 4 lumbar 5 vertebral bodies, 14 cases of lumbar 5 sacral 1 vertebral bodies; lesions invaded 3 vertebral bodies 10 cases, including 5 cases of lumbar 3-5 vertebral body and 5 cases of lumbar 4-5 sacral 1 vertebral body. The 42 patients in this group were combined with different degrees of cauda equina or nerve root compression, that is, lower limb sensory, motor, reflex or anal sphincter dysfunction, including 42 cases of sciatic nerve tension and 24 cases of cauda equina compression. After drug treatment, the systemic symptoms improved However, the local symptoms did not improve and underwent surgical treatment. When 70 patients were admitted to the hospital, the pain score of group A was 7-10 points, with an average of 7.9 ± 0.6 points, and the pain score of group B was 7-10 points, with an average of 8.2 ± 0.2 points.
This clinical study was authorized and approved by the Ethics Committee of the First Affiliated Hospital of Hebei North University, and the patients and their families were informed of the clinical examination and treatment plan, and the informed consent for the treatment plan was signed.
Reagents and Instruments
Brucellosis Rose Bengal Plate agglutination antigen and brucellosis tube agglutination antigen were produced by National Institute for Communicable Disease Control and Prevention of Chinese Center for Disease Control and Prevention; Sheep anti-human IgG serum was produced by Nanfang Reagent Factory in Yuhuan County, Zhejiang Province; Brucellosis anti-human immunoglobulin detection card is produced by Changchun Boxun Biotechnology Co., LTD; tBlood plate is produced by Tianjin Jinzhang Technology Development Co., LTD.; the enrichment culture bottle and the automatic blood culture instrument (BACTEC9050/LABSTAR) are produced by BD Company of the United States; the CRX line machine is produced by The US GE Company produces, the 16-slice spiral CT is produced by the Japanese TOSHIBA Company, and the 1.5TMR is produced by the German Siemens Company.
Laboratory Methods
In this group, 30 patients (42.85%) had normal blood routine, while 15 patients (21.42%) had increased leukocyte count and neutrophils. Leukocyte count decreased and lymphocytosis increased in 40 cases (57.12%). Hemoglobin decreased in 42 cases (67.7%). All patients increased erythrocyte sedimentation rate (25~55 mm/h) and C-reactive protein (45~95 mg/L). The Rose Bengal Plate Agglutination Test (RBPT) was positive in 32 cases (45.71%) and negative in 38 cases (54.29%). The titers of Standard Tube Agglutination Test (SAT) were more than 1:l00 in 49 cases (70%) and less than 1l00 in 21 cases (30%). The latter 21 patients were re-detected by Brucella-antihuman immunoglobulin test (Coomb, s), all with titers above 1:400.
All patients were tested for Brucella bacteriology and drug sensitivity during febrile period after admission. Blood culture was positive in 12 cases (17.14%), and bone marrow culture was performed in 58 cases with negative blood culture, of which 23 cases were positive (39.66%). In group B, 22 patients (52.38%) were positive for intrafocal inflammatory granuloma or abscess sampling culture during operation, Under the microscope of Brucella G staining oil, the morphology is small Gram-negative bacillus, without buds, capsule and flagella, and Jim staining is purple (Figure 1),
Figure 1 Bacterial culture of Brucella was positive. The morphology of Brucella G stained oil microscope was Gram-negative small coccobacillus.
It was sensitive to doxycycline, rifampicin, streptomycin, penicillin and sulfamemethylisooxazole, but not to isoniazid, ethambutol, pyrazinamide and amikacin. The patients in this group were negative for rheumatoid factor, bone-derived alkaline phosphatase, human tissue-identical antigen, and antihemolytic streptococcin O.
Imaging Examination Methods
70 patients in this group underwent X-ray, CT, MRI and Dual energy X-ray Absorptiometry (DXA) examinations. X-ray films showed 57 cases (81.42%) of patients with narrow intervertebral space and irregular bone destruction at the edge of the vertebral body (Figure 2),
Figure 2 Brucellosis at L3-5. X-ray showed multifocal, wormlike or saw-like destruction of bone at the edge of the vertebral body, clear and sharp lesion edges with soft tissue density, narrow intervertebral space, increased density, irregular appearance of upper and lower vertebrae, with a tendency of bone destruction and no dead bone.
Figure 3 L4 Brucellosis spondylitis. CT shows new osteophyte at the edge of the vertebral body and the destruction focus in between constitutes the characteristic performance of “lace vertebrae”.
Figure 4 L4 Brucellosis spondylitis. CT showed periosteal hyperplasia, hypertrophy, and calcification at the edge of the vertebral body, forming “lip shaped” osteophytes
Figure 5 L4 Brucellosis spondylitis. CT showed that the psoas muscle on both sides of the level of vertebral body destruction was widened, and there was abscess formation in it, but it was not obvious, and the fat space around it was clear.
In 13 patients (18.57%), the bone at the edge of the vertebral body was stiffened like a bird’s beak, which was connected with the edge of adjacent vertebral body hyperplasia to form a bone bridge, and 11 patients (15.71%) had poor lumbar stability. CT showed 53 cases (75.71%) patients with vertebral edge disease have size about 2~6 mm multiple focal bone destruction, bone destruction around focal sclerosis of bone hyperplasia, bone of new born stove and new bone broken, the whole edge vertebral bodies like lace structure formation “lace vertebral (Figure 3)”; In 17 cases (24.28%), intervertebral disc lesions showed isodense shadows, articular cartilage surface sclerosis and hyperplasia, proliferated bony protruding toward the edge of the vertebral body to form “lip”-shaped osteophytes, anterior longitudinal ligament and paravertebral sides were calcified, and there were osteophytes connect (Figure 4); In this group, 18 patients (25.71%) had widened paravertebral muscles with abscess formation and clear surrounding space, but no abscess drainage imaging (Figure 5).
MRI showed that 70 patients with diseased vertebral bodies and intervertebral discs showed heterogeneous signals, in 18 cases, paraspinal features were thin and irregularly enhanced abscess walls and abnormal signals in poorly defined soft tissues, T1WI showed low signal, and T2WI showed high signal; Eleven patients had poor lumbar spine stability and spondylolisthesis; 42 patients showed uneven hypersignal in the vertebral body, intervertebral disc, and spinal canal on T1WI, T2WI, and fat pressure images, and the corresponding plane dura or nerve root compression (Figure 6).
Figure 6 L3-5 Brucellosis spondylitis. MRI showed thin irregularly enhanced abscess wall and soft tissue abnormal signal with ill-defined borders around the spine, low signal on T1W, high signal on T2W, and heterogeneous high signal in vertebral body, intervertebral disc, appendix and spinal canal on fat-pressed images , the corresponding spinal cord plane is compreressed.
Of the 70 patients examined by DXA, 24 had low bone mass of -2.5 < T value < -1.0, 40 had osteoporosis T-value ≤ -2.5, 40 had osteoporosis T-value ≤ -2.5, and 6 had severe osteoporosis T-value ≤ -2.5+ brittle fractures (2 distal radius fractures and 2 proximal humerus fractures).
Pathological Examination
For 42 patients in group B who underwent surgical treatment, the abscess, inflammatory granuloma, and diseased intervertebral disc tissue scraped during the operation were sent for pathological examination. Microscopically, histiocytic hyperplasia, proliferative nodules and granuloma formation can be seen in the lesion area, with a large number of lymphocytes, neutrophils, monocytes, and eosinophils infiltrating, and nodular lesions consisting of sheets of epithelial cells can be seen (Figure 7), consistent with the histological manifestations of brucellosis [1].
Figure 7 Brucella spondylitis. Under the HE×200 optical microscope, histocytes hyperplasia, proliferative nodules and granulomas were seen in the lesion area, and monocytes, lymphocytes, neutrophils, and eosinophils infiltrated in the lesion area. Nodular lesions composed of sheets of epithelioid cells can be seen.
Treatment Method
Chemotherapy: During chemotherapy, 70 patients in this group were protected with waist braces and rested in bed as much as possible.BS medication was administered in a full-course, sufficient, regular, combined, and multi-channel manner. Penicillin antibiotics with strong penetrating ability of intervertebral disc tissue were used for intravenous infusion for 7 days, and doxycycline 0.1g was taken orally, twice a day, the first dose was doubled, for 56 days.; Rifampicin 0.45g, once/d, continuous administration for 56 d; sulfamemethylisooxazole 1.0g, twice a day, the first dose doubled, continuous administration for 56 d, as a course of treatment, a total of 2-3 courses, 14 d interval [3,4]. Anti-osteoporosis treatment while treating BS, oral calcium carbonate tablet 0.5g, once a day, calcitriol capsule 0.5ug, once a day, zoledronic acid intravenous injection 5mg/bottle, intravenous drip, once every year.
Surgical Treatment: The 42 patients in this group were treated with one-stage debridement combined with posterior spinal internal fixation on the basis of standard chemotherapy. The operation was performed by posterior internal fixation first, followed by debridement and intertransverse process bone graft fusion. Routine surgery exposes the spinous process, lamina, articular process, and one vertebral body above and below the lesion, and accurately places pedicle screws after fluoroscopy positioning with a C-arm X-ray machine. For vertebral bodies with severe osteoporosis, bone cement can be cured Re-fixation, if the bone destruction focus of the diseased vertebra is small, and the bone quality of the vertebral body and pedicle at the place where the screw is placed is good, the diseased vertebra can be placed with pedicle screws coated with streptomycin on the surface; If the degree of vertebral damage is severe or the spine is unstable, one vertebral segment above and below the lesion should be fixed.
The affected vertebral lamina was decompressed to reveal the dural capsule and nerve root of the diseased segment, the abscess and inflammatory granuloma in the vertebral canal were removed, the infected intervertebral disc tissue or the damaged cartilage plate were scraped, and the abscess or inflammatory granuloma tissue and the lesion of the vertebral anterior margin (behind the anterior longitudinal ligament) were carefully scraped with the curette of different angles under the guidance of the C-arm X-ray machine. After repeated rinsing of the lesion with gentamicin rinsing saline, the lesion clearance behind the anterior longitudinal ligament, in front of the vertebral body, was observed through intervertebral foraminoscope; otherwise, the lesion clearance was performed again. Intervertebral bone grafting was performed on the bone of the intraoperative laminectomy. The diseased tissue removed during the operation was sent for pathological examination. The patient remained in bed after surgery, wore the protection of the iliothoracolumbar brace 3 weeks after surgery, and gradually sat up and got out of bed. Within 3 months after surgery, the principle of “less activity and more bed rest” was still adopted.
Hyperbaric oxygen (HBO) adjuvant therapy: HBO adjuvant therapy was given to 28 patients in group A on the 1st day of standardized chemotherapy and 42 patients in group B on the 7th day after surgery. The patients were given air pressure for 30min to 1.2MPa, constant pressure oxygen inhalation for 30min, rest for 10min, pressure oxygen inhalation for 30min again, and then decompression for 30 min to 0.03Mpa. Rest for 5min and then reduce to 0 Mpa, once a day. During HBO treatment, the oxygen absorption concentration of patients was maintained at no less than 90%. 14 days was a course of treatment, and the second course of treatment was performed at an interval of 14 days, and the second course of treatment lasted for 10 days, for a total of 2 courses [5].
Evaluation Method of Curative Effect
The time points of patients in this group before treatment (or before operation) and after treatment (or after operation) at 1 month, 3 months, 6 months, and 12 months were used as followup and evaluation points. The evaluation content includes pain score, imaging score, laboratory index evaluation, and clinical curative effect evaluation. Pain scores were performed at all time points, using Visual Analogue Scales (VAS) method, the score range was 0-10, with 0 being no pain and 10 being severe pain. Abilities of daily living included activity level, whether the patient needed to wear an iliothoracic lumbar brace when sitting up or getting out of bed, how long the patient tolerated walking, the ability to walk up and down stairs, the ability to stand up from a seated position, and the ability to return to preoperative nonphysical labor during the first 3 months. The imaging score was quantified by the indicators observed in MRI review at 3, 6, and 12 months after treatment (or after surgery). The score of good spinal stability, inflammatory absorption of the diseased vertebra and intervertebral space, good repair of damaged vertebrae lesions, no inflammatory granuloma compression of the spinal dura or nerve root, and no abscess of the paravertebral soft tissue were 1 point, total 5 points, and 0 points, respectively [6]. For the evaluation of laboratory indicators, recheck whether the SAT titer is normal, whether the RBPT is negative, and whether the CRP is decreased after treatment (or postoperative) 3 months, 6 months, and 12 months.
Clinical efficacy was evaluated according to the criteria of cure, improvement and ineffective [6]: (1) Cure: normal body temperature, complete relief of lumbago, VAS score 0, recovery of daily living ability, MRI imaging score 5, X-ray showed good spinal stability; RBPT negative, SAT titers normal, CRP normal. (2) Improvement: The body temperature was normal, the lumbago was relieved, the VAS score was 1-4, and the daily living ability was better than before treatment. MRI showed stable spine, no inflammation of the dural membrane and nerve root compression, no paraspinal abscess, absorption or partial absorption of inflammation, and repair of bone damage. The imaging score was 3-4, RBPT negative, SAT titer and CRP improved compared with before treatment. (3) Invalid: Normal or abnormal body temperature, poor relief of lumbago, VAS score ≥ 5, poor recovery of daily living ability, MRI showed no absorption of vertebral body and intervertebral inflammation, no repair of bone lesion, inflammatory granuloma compression of dural membrane or nerve root, paravertebral soft tissue with or without abscess, stable or unstable spine, imaging score 0-2. RBPT, SAT titer and CRP showed no significant or no improvement compared with before treatment.
Statistical Methods
SPSS15.0 statistical software was used for analysis. Measurement data obeying or approximately obeying normal distribution were represented by (x±s). Analysis of variance was used for inter-group comparison, and SNK-q test was used for pair-to-group comparison. Repeated measurement analysis of variance was used for multiple measurements at different time points, and c2 test was used for counting data. The test level was 0.05.
RESULT
Follow-Up
All 70 patients in this group were misdiagnosed at the first visit, and 91.42% of them were diagnosed as lumbar tuberculosis in 64 cases. The patients in this group were clinically diagnosed after asking about medical history, clinical manifestations, imaging findings, laboratory tests and/or pathological examinations. 28 cases (40%) in this group received standard chemotherapy as non-surgical treatment; The remaining 42 cases (60%) had indications for surgery and had symptoms of cauda equina or nerve root injury. After 2-4 weeks of standard chemotherapy, the symptoms of cauda equina or nerve root injury did not improve significantly. The patients underwent surgical treatment, and the surgical incision was removed 12-14 days after surgery, and the healing was good without complications. Postoperative standard chemotherapy for 2 courses. All patients were evaluated and followed up at 1,3, 6, and 12 months after treatment (or after surgery). Within 6 months, all patients in this group were followed up, and within 12 months, 56 cases (80%) in this group were followed up, including 22 cases in group A and 34 cases in group B; No recurrence, broken nails, broken rods, or sinus canal were observed in the patients during late follow-up. The intervertebral bone graft healed well and the spine was stable.
Comparison of VAS Scores before and After Treatment between the Two Groups
The comparison of VAS scores between the two groups before and after treatment is shown in (Table 1). VAS scores of the two groups decreased gradually with the follow-up time. VAS scores of group B were significantly different from those before treatment at different time points after surgery, with statistical significance (P < 0.05), while there was no difference between group A and before treatment within 1 month (P > 0.05), and there were differences between group A and before treatment at 3 months, 6 months and 12 months. There was statistical significance (P < 0.05). There was significant difference between the two groups at the same follow-up time point, and there was statistical significance (P < 0.05).
Comparison of Imaging Scores before and After Treatment between the Two Groups
The comparison of imaging scores before and after treatment between the two groups is shown in (Table 2). Before treatment, MRI of 28 cases in group a showed inflammatory infiltration of the affected vertebra and intervertebral space, 8 cases had paravertebral abscess and small bone lesion, but no spinal instability and dural nerve compression. The average imaging score was 3.62 ± 0.13; Three months after treatment, vertebra lesion infiltration, intervertebral space infection and abscess absorption were not obvious, and bone lesion was not repaired, and there was no statistical significance compared with before treatment (P > 0.05). 6 months after treatment, vertebra inflammatory infiltration, intervertebral infection and abscess gradually absorbed, and bone damage lesions began to repair. The average imaging score was 4.01 ± 0.03, which was statistically significant compared with before treatment and 3 months after treatment (P < 0.05). At the last follow-up, the vertebral inflammation, intervertebral infection and abscess disappeared, the bone lesion was repaired, and the average imaging score was 5, which had statistical significance compared with before treatment and 6 months (P < 0.05).
In group B, 42 patients had preoperative inflammatory infiltration and granuloma in the affected vertebrae and intervertebral space, 18 had paravertebral abscess with bone lesion, 11 had spinal instability, and the average imaging score was 0.17 ± 0.03. In addition to the slow repair of the focal area of the vertebral body, 3 months after surgery, the affected vertebra and intervertebral inflammatory infiltration and absorption, spinal stability, no abscess and inflammatory granuloma, imaging score of 3.97 ± 0.03, compared with the preoperative significant difference (P < 0.05). 6 months after surgery, the damaged area of vertebral bone was repaired, and the spine was stable without inflammation, abscess and inflammatory granuloma. The imaging score was 5, which was statistically significant compared with the preoperative and 3 months (P < 0.05). The imaging scores at the last follow-up and 6 months after surgery were the same, and there was no significant difference between them (P > 0.05).
Comparison of Clinical Efficacy between the Two Groups after Treatment
The comparison of clinical efficacy between the two groups after treatment is shown in (Table 3). After treatment, the cure rates of the same group at 6 months, 12 months and 3 months were significantly different (P < 0.05). The clinical cure rate of the two groups at the same time point was statistically significant (P < 0.05).
DISCUSSION
Brucellosis (referred to as brucellosis) is a zoonotic endemic infectious disease caused by Brucella. In recent years, the incidence of the elderly has gradually increased. Because most of the elderly are accompanied by lumbar degenerative joint disease and osteoporosis once infected with brucellosis, the secondary infection of the spine, that is, brucellosis spondylitis, easily occurs. Inflammation invades the osteoporotic vertebral body and easily infiltrates and spreads, forming bone destruction; moreover, the elderly have low physiological functions and low immunity, slow metabolism, mild inflammatory response, easy to form paravertebral abscess or intraspinal abscess. Therefore, the clinical manifestations of BS in the elderly are slow, atypical, long-term, insensitive to drug treatment, recurrent, longterm unhealed, poor in effect, and high in recurrence rate. The clinical and imaging manifestations of BS have many similarities with spinal tuberculosis. It is easy to cause misdiagnosis and mistreatment [1]. All 70 cases in this group were misdiagnosed before admission, of which 64 cases were misdiagnosed as spinal tuberculosis, the misdiagnosis rate was 91.42%. However, as long as clinicians understand and pay attention to the disease, are familiar with the epidemiological characteristics of the disease, and understand its clinical imaging, laboratory and pathological characteristics, it is possible to make a differential diagnosis. Therefore, it is of great significance to deepen the understanding of BS, grasp the first diagnosis, reduce the misdiagnosis rate, it is of great significance for the diagnosis of the disease and for timely and effective standardized drug treatment and precise surgical intervention.
Establish a BS Standardized Clinical Diagnosis System
It is very important to inquire about the medical history of elderly patients with BS. Most patients had contact with brucellosis livestock, cattle, sheep or livestock products, or traveled to brucellosis-endemic areas before the onset of the disease. The clinical manifestations were systemic symptoms and local symptoms. Systemic symptoms are the symptoms of brucellosis poisoning, manifested as flaccid low-grade fever, loss of appetite, headache, fatigue, anemia, night sweats, most of them are accompanied by reproductive system and respiratory system infection, testis, surrounding lymph nodes, liver and spleen can be enlarged, multiple and wandering pain is manifested in the muscles of the whole body and the major joints of the hip, knee, ankle, and shoulder; the local symptom is the symptom of infectious spondylitis, the lumbar spine is the most common, and the low back pain is severe and persistent, with deep tenderness next to the spinous process of the diseased vertebra, pain with heavy percussion, and low back pain, muscle spasm, limited spinal flexion, extension and rotation, patients are often in a passive fixed posture standing or lying down, there may be psoas abscess formation and corresponding nerve root radiating pain in the lower extremities or symptoms of cauda equina compression[7-8].
The most commonly used serological methods for laboratory examination of brucellosis are RBPT and SAT. Due to the low positive rate of RBPT, this group was 45.71%, SAT is mostly used clinically, and patients can be positive within 2 weeks after the onset of the disease. The positive rate of SAT in the acute phase is about 80%, while that in the chronic phase is about 30%. The positive rate of SAT is less affected by other factors, even if the course of the disease Longer or have received anti-infective drug treatment may also have a higher positive rate. Therefore, SAT can be used as the most commonly used examination method for clinical diagnosis and differential diagnosis of brucellosis. The patients in this group are all elderly people with poor body response ability and insensitivity, and long medical history, the positive rate of SAT is 57.14%, therefore, brucellosis cannot be ruled out for those who are negative for SAT; although Coomb’s has a high positive rate, the clinical laboratory examination is limited due to the influence of hospital equipment conditions, technical level and reagents, so it cannot be used as a routine clinical examination method. Bacteriological examination of brucellosis is the gold standard for diagnosis and has the highest value, but the detection rate of blood culture ranges from 10% to 74% [9], and the positive rate of blood culture in this group is only 17.17%, the positive rate of bone marrow culture was 39.65%, and the positive rate of inflammatory granuloma or abscess culture in the lesion was 52.38%. Combined with systemic infection and whether they received anti-infection treatment before blood collection, 91.42% of patients in this group were misdiagnosed as spinal tuberculosis before admission and were treated with antituberculosis drugs isoniazid and rifampicin. The drug sensitivity results of bacterial culture in this group showed that Rifampicin is also a drug sensitive to brucellosis, which may be the main reason for the low positive rate of blood culture. Therefore, for clinical bacteriological culture, lesion sampling or bone marrow culture is appropriate to increase the positive rate.
Imaging examination Early X-ray films only showed lumbar degeneration and vertebral osteoporosis, no spinal infection, and generally changed after 6 to 8 weeks of onset. Once X-ray signs appeared, they developed rapidly, and the vertebral body Marginal bone destruction and intervertebral space stenosis mainly, bone destruction concentrated on the upper or lower edge of the vertebral body, manifested as progressive intervertebral space stenosis, involving two adjacent vertebral bodies, and may be accompanied by destruction of intervertebral facet joints Caused spinal instability, but no vertebral body compression or wedge-shaped deformation, bone bridge was shown in the later stage, extremely sclerotic, but rarely bony fusion, 53 cases in this group showed narrow intervertebral space, vertebral edge bone destruction, 17 cases of vertebral body Marginal bone hyperplasia forms a bone bridge; CT examination can clearly show the degree of bone destruction in the lesion, whether there is a cavity and paravertebral abscess formation, the intervertebral disc is destroyed as an isodensity shadow, the pedicle is not destroyed, and the periosteum at the edge of the vertebral body is hypertrophic and calcified due to inflammation stimulation, forming a “lip-like” Osteophytes, new bone at the edge of the vertebral body interlaced with small destructive foci to form “lace vertebrae”, “lip-shaped” osteophytes and “lace vertebrae” constitute the characteristic manifestations of BS, and CT is unique in showing paravertebral abscesses around the lesion.
The advantages of CT-guided puncture abscess and biopsy are also available. In this group, 53 cases had the characteristic manifestation of “lace vertebrae” and 17 cases formed “lipshaped” osteophytes, and 18 cases showed paravertebral abscesses; The main value of MRI examination is to display abnormal signals at the stage of inflammatory infiltration, to determine the involvement of the spine and the scope of lesions, and to clearly show vertebral osteomyelitis, intervertebral disc destruction, paravertebral abscess, and intraspinal epidural abscess. Damaged intervertebral disc or inflammatory granulation tissue protrudes into the vertebral canal, causing compression of the corresponding plane dural sac [2,7,8]. MRI can guide surgical treatment, 44 cases of this group MRI showed dural sac or nerve root compression. Pathological manifestations include histiocytosis and non-tuberculous granuloma formation. Microscopically, infiltration of neutrophils, monocytes, lymphocytes, and eosinophils was observed, and proliferative nodules composed of patches of epithelioid cells were visible. In this group of 42 patients, pathological examination was performed on all lesions removed during surgical treatment, which conformed to the histological findings of brucellosis [1,7].
Currently, there is no unified diagnostic standard for BS, especially in elderly patients with atypical clinical symptoms and mild metabolic reactions. The diagnosis of this disease should be combined with epidemiological history, clinical symptoms, imaging findings, laboratory tests, pathological tests, or etiological tests for a comprehensive diagnosis [10,11]. Actively perform immunological, pathological, and pathogenic examinations on suspected cases to make clinically diagnosed cases confirmed [12]. The 70 elderly patients in this group were all in line with the confirmed cases of BS.
Establish a BS Treatment Strategy System
BS is infectious spinal discitis or spondylitis caused by brucellosis attacking the spine. Senile BS is not only a problem of spinal infection but also a chronic infectious and wasting disease. The elderly are a special group, often accompanied by anemia, osteoporosis, heart, brain and lung and other multi-organ system diseases, on the basis of multidisciplinary collaborative synchronous treatment of medical diseases, strengthen supportive therapy to supplement nutrition and improve immunity, and carry out integrated joint standardized treatment of osteoporosis and BS.
Scholars at home and abroad have recognized that chemotherapy is the preferred method for the treatment of BS, and most patients can be cured through simple chemotherapy or conservative treatment [3,9,13]. Many scholars at home and abroad have observed in practical clinical applications that “tetracycline + streptomycin” or similar drugs recommended by the WHO joint bulletin are used to replace the treatment of brucellosis. The effective rate of this recommended chemotherapy method is only 60%, and the long-term efficacy is not good, and the recurrence rate is about 40% [4,14]. According to domestic scholar Yang Xinming’s clinical research on “re-evaluation of the influence of drug compatibility and course of treatment on the clinical efficacy of brucellosis spondylitis” [15], the current ideal chemotherapy regimen is: doxycycline 0.1g, once a day, Doubling for the first time, for 56 days in a row; sulfamethoxazole 1.0g, twice a day, for 56 days; rifampicin 0.6g, once a day, for 56 days; “Doxycycline + sulfamethoxazole + rifampicin” is the first choice of chemotherapy, which is in line with the principles of the first choice specified in the “Guidelines for Antimicrobial Therapy” [16,17]; the literature reports that the effective rate and cure rate of this chemotherapy regimen in treating BS are about 95% and 85% [4]. Foreign scholar Ioannou has confirmed through clinical research and analysis that no matter which chemotherapy regimen is used clinically, longer-term chemotherapy is positively correlated with a lower failure rate, and the results of this study are consistent with Seyed’s literature reports [17,18]. The patients in this group were treated with this chemotherapy regimen for 2 courses regardless of conservative treatment or surgical treatment, with an interval of 7 days between the 2 courses of treatment. The cure rate of BS treated with this regimen was about 86.84%, and the improvement rate was 100%. On the basis of standardized chemotherapy, simultaneous administration of calcium agents, active vitamin D, and bisphosphonates to treat osteoporosis can increase the bone density and strength of the vertebral body, which is conducive to controlling the spread of inflammation, promoting bone repair, and improving the holding power of surgical internal fixation.
Surgical treatment should be performed for patients with BS who do not improve local symptoms after initial drug treatment and have the following clinical symptoms [7,19-22]: (1) Patients with psoas major muscle abscess or paravertebral abscess and large and difficult to absorb ;(2) Those with intractable pain in the lower back caused by the destruction of the intervertebral space; (3) Inflammatory granulomas, abscesses or necrotic intervertebral discs compressing the spinal cord or cauda equina or nerve roots in the spinal canal; (4) Spinal instability due to vertebral bone destruction or articular process destruction; (5) Patients with other infectious spondylitis requiring surgery. In this study, 42 cases (60%) in group B were complicated with intractable pain symptoms caused by different degrees of cauda equina, nerve root compression, and intervertebral space damage. After conservative treatment for 2 to 4 weeks, the symptoms did not improve. After 2 to 4 weeks of conservative treatment, the symptoms did not improve. Imaging findings showed that 11 patients with BS had poor lumbar stability with spondylolisthesis, 18 patients had paravertebral abscess formation, and 42 patients had inflammatory granulation tissue, abscess, or damaged intervertebral disc protruding into the spinal canal, causing compression of the dural sac or cauda equina, or nerve root, that is, 42 patients in Group B met the surgical indications, and their surgical strategy was formulated closely around the four major treatment goals of “curing the lesion, reconstructing spinal stability, restoring spinal cord function, and rapid recovery” [19]. Clinical studies have shown that postoperative recurrence of BS is related to the destruction of spinal stability [23]. In the past, simply relying on lesion debridement to promote infection recovery is no longer the sole purpose of surgical treatment of this disease [19,20,22-25].Therefore, in this study, 42 cases in group B were treated with one-stage debridement combined with posterior pedicle fixation. The operation completely removed the infected lesions and relieved the compression of the nervous system in the spinal canal, and at the same time performed posterior pedicle fixation, and the lesion was restored. Segmental spine stability not only relieves pain, but also creates a stable environment for bone repair, which is conducive to the rapid recovery of patients, and reduces the complications such as risk of heart and brain diseases, gastrointestinal dysfunction, hypostatic pneumonia, bed sores and deep vein thrombosis of the lower extremities occurred.
In early initial treatment cases, patients with major systemic symptoms and mild local symptoms of the spine have imaging findings that as long as the spine is stable, inflammatory changes in the intervertebral disc are not damaged, and the vertebral bone destruction or abscess is small, without neurological dysfunction. Choosing non-surgical treatment (chemotherapy alone) can achieve better results. That is, chemotherapy alone can obtain better curative effect [26]. In this study, 28 cases in group A had no surgical indications, and MRI showed that only the vertebral body and intervertebral disc showed uneven signal, that is, the vertebral body and intervertebral space inflammatory infiltration, no large bone destruction focus, no paravertebral or intraspinal abscess, and no spinal cord Or the cauda equina and nerve root are compressed, and the full-course standardized drug treatment strategy has achieved good results. Clinical application and literature [3,5] prove that HBO adjuvant chemotherapy can increase the diffusion distance and penetration of oxygen in diseased vertebral tissue, inhibit the growth and reproduction of Brucella, reduce inflammation and edema, and promote microcirculation and tissue metabolism, enhance the bactericidal ability of white blood cells, and have a synergistic effect with drugs for treating brucellosis. While improving the curative effect of drugs, it also promotes the quality and quantity of osteogenesis in the bone lesion repair area, especially for elderly BS patients with heart, brain, lung, and osteoporosis, the cure rate has been significantly improved, and its common complications have been significantly reduced, with a better therapeutic effect than chemotherapy alone [5].
Clinical Efficacy Evaluation of Implementing BS Treatment Strategy System
The results of VAS scores before and after treatment in the two groups are shown in (Table 1). In Group A, there was no difference between the treatment within 1 month and before treatment (P > 0.05), while the differences at other time points were statistically significant (P < 0.05). However, in Group B, there was a statistically significant difference between each time point and before treatment (P < 0.05), indicating that over time, both treatment methods could gradually reduce the VAS score and effectively alleviate pain. There was a statistically significant difference between Group B and Group A at the same time point (P < 0.05), this indicates that the reconstruction of spinal stability based on focus removal in Group B can immediately and effectively relieve severe and intractable pain caused by intervertebral space infection, spinal instability, or inflammatory stimulation of nerve roots before surgery, and completely relieve the pain after 3 months; however, after 3 months in Group A, the pain gradually began to relieve, and after 12 months in some patients, the pain still did not completely relieve, indicating that the treatment method in Group B can quickly relieve the pain in a short time, and its effect is significantly better than that in Group A.
The imaging scores of the two groups before and after treatment are shown in (Table 2). As time goes by, there is a statistically significant difference between Group A after 6 months of treatment and before treatment (P < 0.05), indicating that the treatment method of Group A can also gradually absorb the inflammatory infiltration of the vertebral body and the infection of the intervertebral space. But it only takes a long time and course of treatment to have an effect, and in terms of time and imaging changes, it is not as effective as postoperative chemotherapy in Group B. In group B, in addition to the poor repair of the damaged vertebrae due to the short postoperative period of 3 months, the inflammatory infiltration and absorption of the diseased vertebra and intervertebral space, the stability of the spine, no abscess and inflammatory granuloma, and the imaging score gradually increased, indicating that B The postoperative MRI imaging review of the group’s treatment strategy showed that surgery can completely remove intervertebral space inflammation, spinal canal abscess, inflammatory granuloma, and paravertebral abscess, timely eliminate infection lesions and relieve nerve compression, while pedicle internal fixation Immediate stability in the early stage and long-lasting stability in the later stage can be achieved with bone grafting. With the passage of time, vertebral bone destruction lesions can be repaired relying on their own repair ability or bone grafting. Imaging at the 12month after surgery showed that the lesion area was well repaired.
The results of clinical curative effect after treatment of the two groups are shown in (Table 3). With the passage of time, the number of improved and ineffective patients in group a gradually decreased, the number of cured patients gradually increased, and the cure rate increased significantly. There was a statistically significant difference between the cure rate at the latter time point and the cure rate at the previous time point (P < 0.05), indicating As long as non-surgical indications are met, standardized chemotherapy alone has a good curative effect on elderly patients with BS. Comparing the two groups at the same time point, 24 of the 42 cases in group B were cured within 3 months, 18 cases were improved, and the cure rate was 57.14%, indicating that this surgical strategy has a significant effect on improving the early cure rate of BS compared with group A (P < 0.05); The cure rate of group B at subsequent time points was significantly better than that of group A (P < 0.05), indicating that no matter in the early or late stage, this surgical strategy has a relatively good cure rate for elderly BS patients with surgical indications in terms of relieving pain, restoring daily activity abilities, and damaging neurological functions. Therefore, timely surgery is extremely beneficial to remove lesions, control infection, restore cauda equina and nerve root functions, reduce disability rate, and increase cure rate [22,25,26].
FUND PROGRAM
Provincial Government Aid Clinical Medical Talents Cultivation and Basic Research Projects of Hebei Province (361009); Key Project of Technical Research and Achievement Transformation in Health Field of Hebei Province of Hebei Province (zh2018014); Medical Application Technology Tracking Project of Hebei Province (G2018074); Medical Science Research Project of Hebei Province (20200504).
REFERENCES
- Xinming Yang, Xianyong Meng, Wei Shi, Yakun Du, Lei Zhang, Yaoyi Wang. The Comparison of the Manifestation of the Clinical Imageology and Pathology between the Brucellar Spondylitis and the Spine Turberculosis. Surgical Science. 2014; 5(2): 60-69. DOI: 10.4236/ss.2014.52014.
- Yang Xin-ming, Wei Shi, Wang Xiao-yi. Imaging Classification and Clinical Significance of Brucellosis Spondylitis. J Spine. 2014; 3(3): 172-177. DOI: 10.4172/2165-7939.1000172.
- Xin-Ming Yang, Wei Shi, Xian-Yong Meng, Ying Zhang, Ya-Kun Du, Lei Zhang, et al. The Assessment of the Clinical Effect of the Drug Compatibility and Course of Treatment to the Brucellar Spondyliti. Surgical Science. 2013; 4(1): 92-99. DOI: 10.4236/ss. 2013.41017.
- Saltoglu N, Tasova Y, Inal AS, Seki T, Aksu HS. Efficacy of rifampicin plus doxycycline versus rifampicin plus quinolone in the treatment of brucellosis. Saudi Med J. 2002; 23(8): 921-924. PMID: 12235463.
- Xin-ming Yang, Ying Zhang, Xian-yong Meng. Clinical Effect of Hyperbaric Oxygen Intervention on Brucellosis Spondylitis. Chinese Journal of Nautical Medicine and Hyperbaric Medicine. 2013; 20(6): 348-351. DOI: 10.3760/ cma.j.issn.1009-6906.2013.04.008.
- Xin-ming Yang-Xian-yong Meng-Chang-bo Hu. Diagnostic and Therapeutic Value of MRI Image Typing in Brucellosis Spondylitis. Chinese Journal of Anatomy and Clinics. 2016; 21(2): 101-108. DOI: 10.3760/ cma.j.issn.2095-7041.2016.02.003.
- Xin-ming Yang, Wei Shi, Ya-kun Du. Clinical Imaging Findings and Surgical Treatment of Brucellosis Spondylitis. Chinese Journal of Orthopedics. 2008; 28(1): 35-40. DOI: 10.3321/j.issn:0253- 2352.2008.01.008.
- Xian-Yong Meng, Xin-Ming Yang, Peng Zhang, Chang-bo Hu. Observation of 38 Cases of Brucellar Spondylitis with Nerve Damage. Orthopedic Journal of China. 2015; 23(5): 393-401. DOI: 10.3977/j. issn.1005-8478.2015.05.03.
- Turgut M, Turgut AT, Ko?ar U. Spinal brucellosis: Turkish experience based on 452 cases published during the last century. Acta Neurochir (Wien). 2006; 148(10): 1033-1044; discussion 1044. DOI: 10.1007/ s00701-006-0877-3. Epub 2006 Sep 8. PMID: 16944052.
- Peng Zhang, Xin-Ming Yang, Xian-Yong Meng. Progress in Diagnosis and Treatment of Brucobacterial Spondylitis. Chinese Journal of Spine and Spinal Cord. 2013; 23(11): 1029-1032.DOI: 10.3969/j. issn.1004-406X.2013.11.15.
- Merdan Mermaiti, Jusn Tian, Wei-bin Sheng. Diagnosis and Surgical Treatment of Brucellosis Spondylitis. Chinese Journal of Orthopaedics. 2012; 32(4): 323-330. DOI: 10.3760/cma.j.is sn.0253-2352.2012.04.006.
- Ye Zhang, Xin-Ming Yang, Wei Shi. Diagnosis and Treatment of Lumbar Brucellosis Spondylitis. Chinese Journal of Experimental and Clinical Infectious Diseases (Electronic Edition).2014; 8(4): 8-13. DOI: 10.3877/cma.j.issn.1674-1358.2014.04.003.
- Xin-Ming Yang, Wei Shi, Ya-kun Du. Clinical Observation of Brucellar Spondylitis. Chinese Journal of Endemiology. 2008; 27(6): 699-703. DOI:10.3760/cma.j.issn.1000-4955.2008.06.034.
- Solera J, Geijo P, Largo J, Rodriguez-Zapata M, Gijón J, Martinez-Alfaro E, et al. A randomized, double-blind study to assess the optimal duration of doxycycline treatment for human brucellosis. Clin Infect Dis. 2004; 39(12): 1776-1782. DOI: 10.1086/426024. Epub 2004 Nov 19. PMID: 15578399.
- Xin-Ming Yang, Wei Shi, Xian-yong Meng. Re-evaluation of the Effect of Drug Compatibility and Course of Treatment on Clinical Efficacy of Brucellosis Spondylitis. Chinese Journal of Modern Applied Pharmacy. 2013; 30(7): 776-781.
- David N Gilbert. The Sanford guided to antimicrobial therapy. Antimicrobial Therapy. 2004; 40: 48-51.
- Ioannou S, Karadima D, Pneumaticos S, Athanasiou H, Pontikis J, Zormpala A, et al. Efficacy of prolonged antimicrobial chemotherapy for brucellar spondylodiscitis. Clin Microbiol Infect. 2011; 17(5): 756- 762. DOI: 10.1111/j.1469-0691.2010.03272.x. PMID: 20518794.
- Smailnejad Gangi SM, Hasanjani Roushan MR, Janmohammadi N, Mehraeen R, Soleimani Amiri MJ, Khalilian E. Outcomes of treatment in 50 cases with spinal brucellosis in Babol, Northern Iran. J Infect Dev Ctries. 2012; 6(9): 654-659. DOI: 10.3855/jidc.2175. PMID: 23000864.
- Xin-Ming Yang, Xian-yong Meng, Ying Zhang. Surgical Treatment of Thoracolumbar Brucellosis Spondylitis. Chinese Journal of Spine and Spinal Cord. 2012; 23(10): 1055-1058. DOI: 10.3969/j.issn.1004- 406X.2012.07.05
- Xin-Ming Yang, Lei Zhang, Ying Zhang. Treatment of Thoracolumbar Brucellosis Spondylitis by Primary Debridement Combined with Posterior Pedicle Internal Fixation. Chinese Journal of Reparative and Reconstructive Surgery.2012; 26(3): 266-271. DOI-CNKI:51- 1372/R.20120229.0859.003.
- Pina MA, Modrego PJ, Uroz JJ, Cobeta JC, Lerin FJ, Baiges JJ. Brucellar spinal epidural abscess of cervical location: report of four cases. Eur Neurol. 2001; 45(4): 249-53. DOI: 10.1159/000052137. PMID: 11385263.
- Katonis P, Tzermiadianos M, Gikas A, Papagelopoulos P, Hadjipavlou A. Surgical treatment of spinal brucellosis. Clin Orthop Relat Res. 2006; 444: 66-72. DOI: 10.1097/01.blo.0000203455.59393.9a. PMID: 16523129.
- Xin-Ming Yang, Lei Zhang, Yong-li Jia. Comparison of Efficacy of Posterior and Anterior Approaches Combined with Debridement and Bone Grafting in Treatment of Lumbar Brucellosis Spondylitis. Chinese Journal of Anatomy and Clinics. 2015; 20(5):428-434. DOI: 10.3760/cma.j.issn.2095-7041.2015.05.013.
- Bouaziz MC, Bougamra I, Kaffel D, Hamdi W, Ghannouchi M, Kchir MM. Noncontiguous multifocal spondylitis: an exceptional presentation of spinal brucellosis. Tunis Med. 2010; 88(4): 280-284. PMID: 20446265.
- Chang-bo Hu, Xin-Ming Yang. Treatment of Single Space Lumbar Brucellosis Spondylitis with One-stage Posterior Debridement and Short Segment Internal Fixation with Intervertebral or Intraarticular Bone Graft. Chinese Journal of Anatomy and Clinics. 2018; 23(2): 110-116. DOI: 10.3760/cma.j.issn.2095-7041.2018.02.005.
- Xin-ming Yang, Xian-yong Meng, Chang-bo Hu. Standardized Diagnosis and Surgical Treatment of Brucellosis Spondylitis. Chinese Journal of Bone and Joint Surgery. 2015; 21(2): 110-114. DOI: 10.3969/j.issn.2095-9958.2016.04-09.